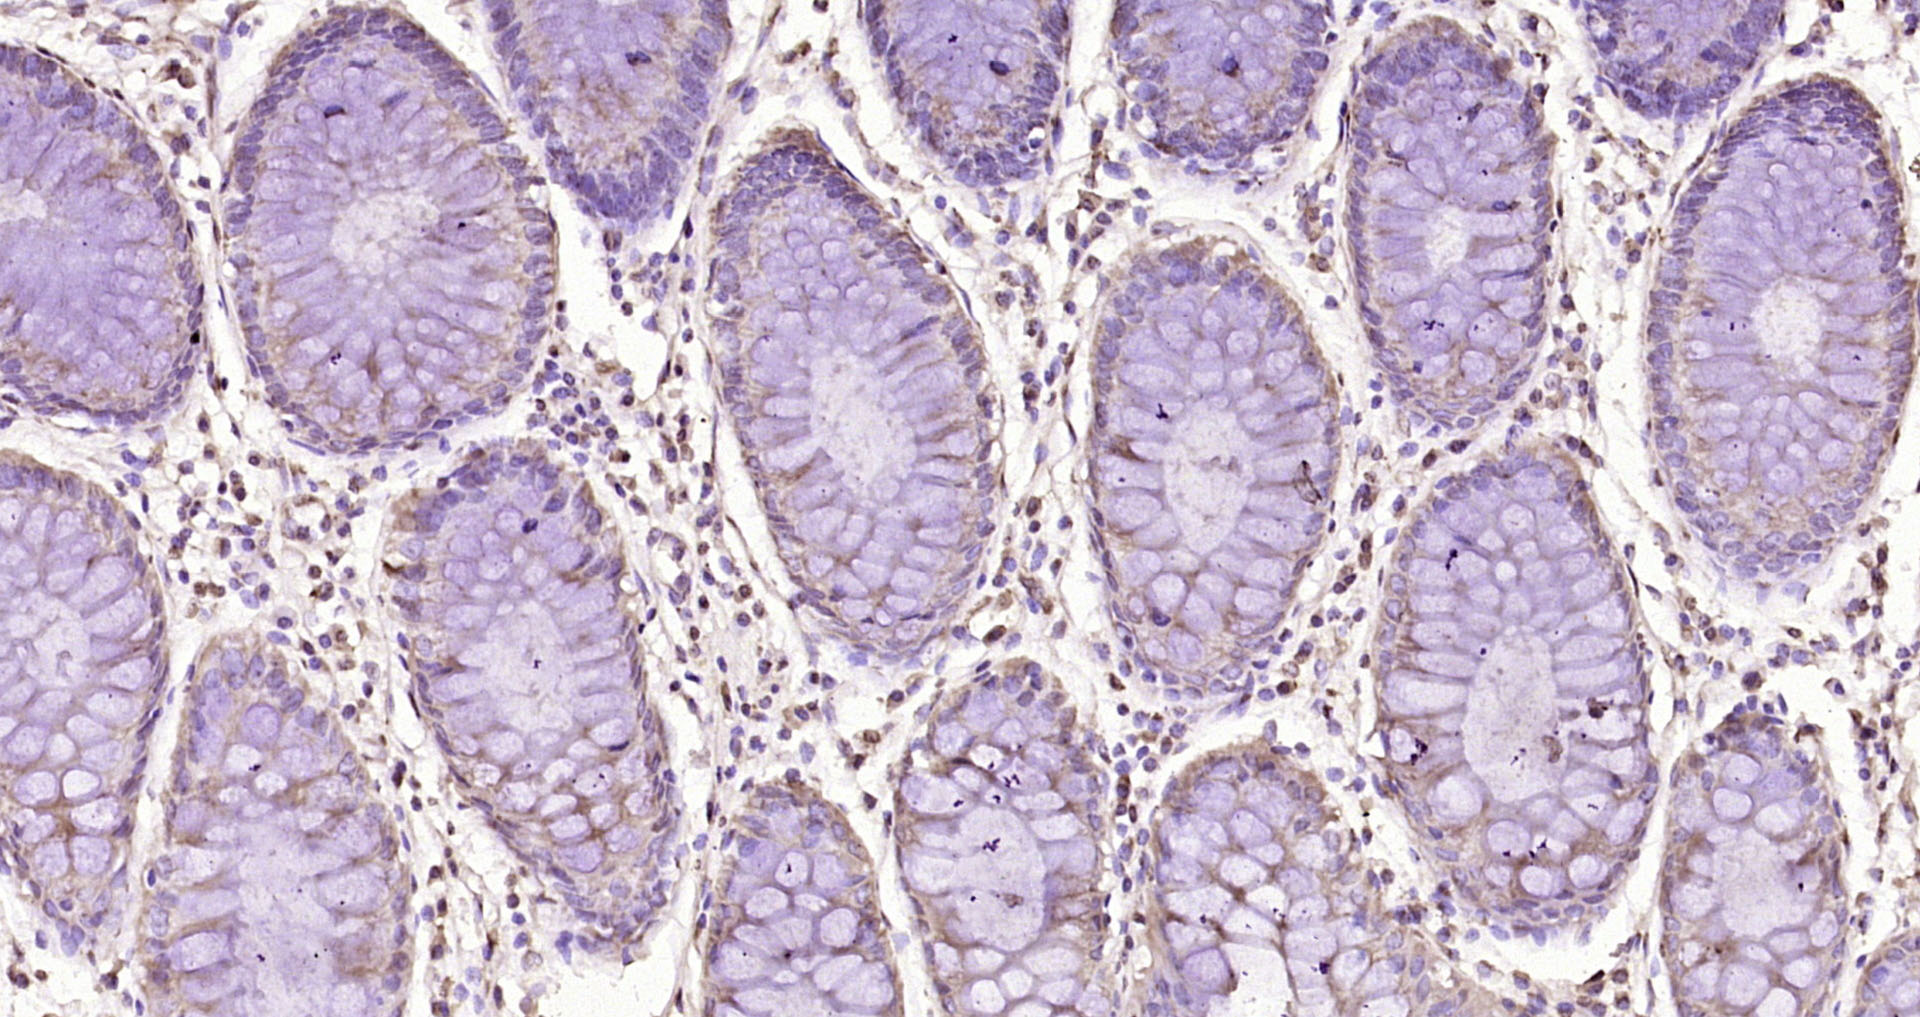
Paraformaldehyde-fixed, paraffin embedded Human colon cancer; Antigen retrieval by boiling in sodium citrate buffer (pH6.0) for 15min; Block endogenous peroxidase by 3% hydrogen peroxide for 20 minutes; Blocking buffer (normal goat serum) at 37°C for 30min; Antibody incubation with CD163L1 Polyclonal Antibody, Unconjugated (bs-21936R) at 1:200 overnight at 4°C, DAB staining.

CD163b Polyclonal Antibody
ORB311332
ApplicationsWestern Blot, ELISA
Product group Antibodies
ReactivityHuman
TargetCD163L1
Overview
- SupplierBiorbyt
- Product NameCD163b Polyclonal Antibody
- Delivery Days Customer16
- ApplicationsWestern Blot, ELISA
- Applications SupplierELISA, WB
- CertificationResearch Use Only
- ClonalityPolyclonal
- ConjugateUnconjugated
- Gene ID283316
- Target nameCD163L1
- Target descriptionCD163 molecule like 1
- Target synonymsCD163B, M160, SCARI2, STAR, WC1, scavenger receptor cysteine-rich type 1 protein M160, CD163 antigen B, CD163 antigen-like 1
- HostRabbit
- Protein IDQ9NR16
- Protein NameScavenger receptor cysteine-rich type 1 protein M160
- Scientific DescriptionCD163b Polyclonal Antibody
- ReactivityHuman
- Storage Instruction-20°C,2°C to 8°C
- UNSPSC12352203